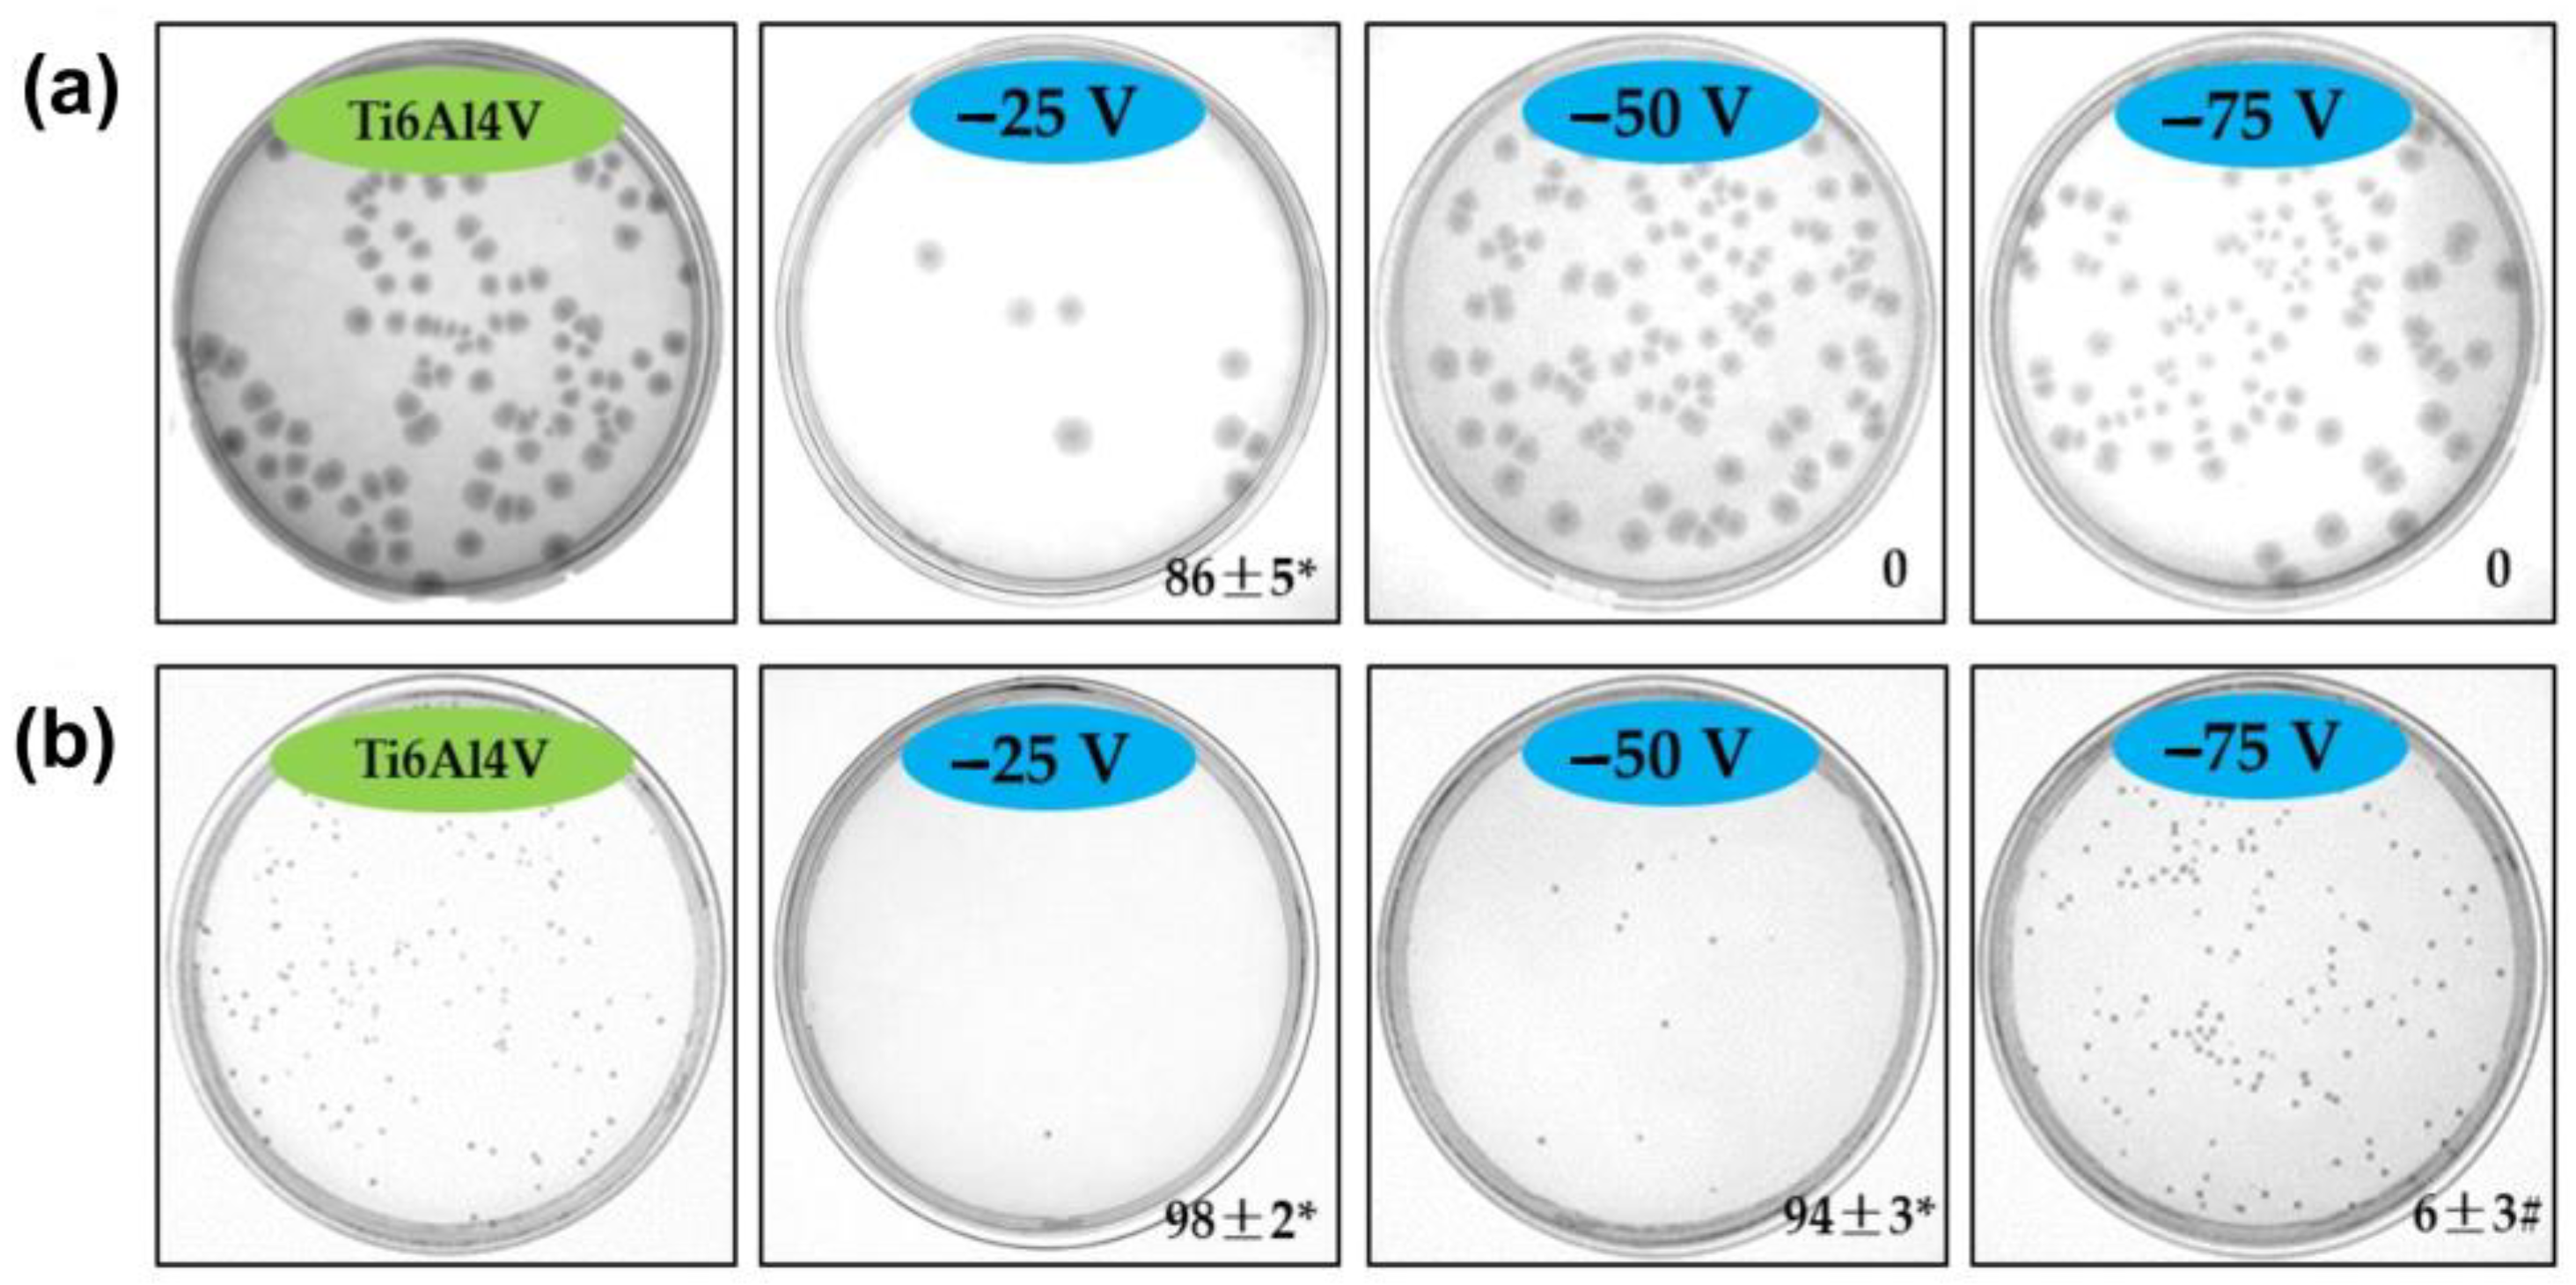
Applsci 14 09578 g010

One-Step Magneton Sputtering of Crystalline Cu-Doped TiO2 Coatings: Characterization and Antibacterial Activity
Abstract
1. Introduction
2. Materials and Methods
2.1. Substrate Material
2.2. Coating Deposition and Temperature Measurements
2.3. Characterization
2.4. Antibacterial Examinations
2.5. Statistical Analysis
3. Results
3.1. Coatings Preparation
3.2. Characterization of the Coatings
3.3. Antibacterial Properties
4. Conclusions
- -
- Summary of findings: Pure anatase, mixed anatase-rutile, or pure rutile-containing Cu-TiO2 coatings were successfully obtained by varying the substrate bias during the one-step direct current magnetron sputtering of the mosaic Ti-Cu target metal in a pure O2 atmosphere. During the deposition, the energy differences between the bombarding positive ions and the depositing atoms play a more significant role in the formation of film phase composition than the thermal mobility of the depositing atoms on the surface. The higher bias leads to thinner coatings with smaller grains, more lattice microstrain, and more defects, which together result in larger water contact angles and hardness values. The samples biased at −75 V had the best coating–substrate adhesion strength, whereas the specimen biased at −50 V showed superior corrosion resistance. The −25 V biased sample with the highest copper content (2.62 wt.%) provided excellent antibacterial activity against both E. coli and S. aureus stains while that obtained at −50 V indicated excellent bactericidal effects only against the Gram-positive germ. These one-step-fabricated Cu-containing TiO2 coatings are appealing because they may achieve multifunctionality by changing the target composition and substrate biasing.
- -
- Limitations: Even with these improvements, several drawbacks were found. The primary limitation is the possible mechanical or electrochemical instability of the coatings in a physiological medium during long-term exposure in the body. Additionally, the long-term antibacterial properties and biocompatibility of the coated implants have to undergo extensive in vitro and in vivo testing.
- -
- Future work: By increasing the copper content in the target, the antibacterial performance of both −50 V and −75 V biased samples can be adjusted. Future research should explore the in vitro integration of the coatings with optimized process production parameters by assessing the molecular biomarkers that can further demonstrate their biomedical benefits.
Author Contributions
Funding
Institutional Review Board Statement
Informed Consent Statement
Data Availability Statement
Conflicts of Interest
References
- Mazur, M. Analysis of the properties of functional titanium dioxide thin films deposited by pulsed DC magnetron sputtering with various O2:Ar ratios. Opt. Mater. 2017, 6, 96–104. [Google Scholar] [CrossRef]
- He, X.; Zhang, G.; Wang, X.; Hang, R.; Huang, X.; Qin, L.; Tang, B.; Zhang, X. Biocompatibility, corrosion resistance and antibacterial activity of TiO2/CuO coating on titanium. Ceram. Int. 2017, 43, 16185–16195. [Google Scholar] [CrossRef]
- Li, N.; Xu, Z.; Zheng, S.; Dai, H.; Wang, L.; Tian, Y.; Dong, Z.; Jiang, L. Superamphiphilic TiO2 Composite Surface for Protein Antifouling. Adv. Mater. 2021, 33, 2003559. [Google Scholar] [CrossRef] [PubMed]
- van Hengel, I.A.J.; Tierolf, M.W.A.M.; Valerio, V.P.M.; Minneboo, M.; Fluit, A.C.; Fratila-Apachitei, L.E.; Apachitei, I.; Zadpoor, A.A. Self-defending additively manufactured bone implants bearing silver and copper nanoparticles. J. Mater. Chem. B 2020, 8, 1589–1602. [Google Scholar] [CrossRef]
- ter Boo, G.-J.A.; Grijpma, D.W.; Moriarty, T.F.; Richards, R.G.; Eglin, D. Antimicrobial delivery systems for local infection prophylaxis in orthopedic- and trauma surgery. Biomaterials 2015, 52, 113–125. [Google Scholar] [CrossRef]
- Wang, H.; Zhao, S.; Zhou, J.; Shen, Y.; Huang, W.; Zhang, C.; Rahaman, M.N.; Wang, D. Evaluation of borate bioactive glass scaffolds as a controlled delivery system for copper ions in stimulating osteogenesis and angiogenesis in bone healing. J. Mater. Chem. B 2014, 2, 8547–8557. [Google Scholar] [CrossRef]
- O’Neill, E.; Awale, G.; Daneshmandi, L.; Umerah, O.; Lo, K.W.H. The roles of ions on bone regeneration. Drug Discov. Today 2018, 23, 879–890. [Google Scholar] [CrossRef]
- Heidenau, F.; Mittelmeier, W.; Detsch, R.; Haenle, M.; Stenzel, F.; Ziegler, G.; Gollwitzer, H. A novel antibacterial titania coating: Metal ion toxicity and in vitro surface colonization. J. Mater. Sci. Mater. Med. 2005, 16, 883–888. [Google Scholar] [CrossRef]
- Jacobs, A.; Renaudin, G.; Forestier, C.; Nedelec, J.M.; Descamps, S. Biological properties of copper-doped biomaterials for orthopedic applications: A review of antibacterial, angiogenic and osteogenic aspects. Acta Biomater. 2020, 117, 21–39. [Google Scholar] [CrossRef]
- Zhang, X.; Yu, Y.; Jiang, D.; Jiao, Y.; Wu, Y.; Peng, Z.; Zhou, J.; Wu, J.; Dong, Z. Synthesis and characterization of a bi-functional hydroxyapatite/Cu-doped TiO2 composite coating. Ceram. Int. 2019, 45, 6693–6701. [Google Scholar] [CrossRef]
- Shimabukuro, M.; Tsutsumi, Y.; Nozaki, K.; Chen, P.; Yamada, R.; Ashida, M.; Doi, H.; Nagai, A.; Hanawa, T. Investigation of antibacterial effect of copper introduced titanium surface by electrochemical treatment against facultative anaerobic bacteria. Dent. Mater. J. 2020, 39, 639–647. [Google Scholar] [CrossRef] [PubMed]
- Zhang, X.; Peng, Z.; Lu, X.; Lv, Y.; Cai, G.; Yang, L.; Dong, Z. Microstructural evolution and biological performance of Cu-incorporated TiO2 coating fabricated through one-step micro-arc oxidation. Appl. Surf. Sci. 2020, 508, 144766. [Google Scholar] [CrossRef]
- Nyamukamba, P.; Okoh, O.; Mungondori, H.; Taziwa, R.; Zinya, S. Synthetic Methods for Titanium Dioxide Nanoparticles: A Review. Titan. Dioxide-Mater. A Sustain. Environ. 2018, 8, 151–175. [Google Scholar] [CrossRef]
- Mathew, S.; Ganguly, P.; Rhatigan, S.; Kumaravel, V.; Byrne, C.; Hinder, S.J.; Bartlett, J.; Nolan, M.; Pillai, S.C. Cu-Doped TiO2: Visible Light Assisted Photocatalytic Antimicrobial Activity. Appl. Sci. 2018, 8, 2067. [Google Scholar] [CrossRef]
- Zhang, W.; Li, Y.; Zhu, S.; Wang, F. Copper doping in titanium oxide catalyst film prepared by dc reactive magnetron sputtering. Catal. Today 2004, 93−95, 589–594. [Google Scholar] [CrossRef]
- Singh, P.; Kaur, D. Room temperature growth of nanocrystalline anatase TiO2 thin films by dc magnetron sputtering. Physica B 2010, 405, 1258–1266. [Google Scholar] [CrossRef]
- Ellmer, K. Magnetron sputtering of transparent conductive zinc oxide: Relation between the sputtering parameters and the electronic properties. J. Phys. D Appl. Phys. 2000, 33, R17. [Google Scholar] [CrossRef]
- Lu, S.; Li, R.; Chai, M.; Wang, J.; Duan, W.; Yao, X.; Zhang, X.; Tang, B. Nanostructured Cu-doped TiO2 with photothermal effect for prevention of implant-associated infection. Coll. Surf. B 2022, 217, 112695. [Google Scholar] [CrossRef]
- Stranak, V.; Wulff, H.; Rebl, H.; Zietz, C.; Arndt, K.; Bogdanowicz, R.; Nebe, B.; Bader, R.; Podbielski, A.; Hubicka, Z.; et al. Deposition of thin titanium–copper films with antimicrobial effect by advanced magnetron sputtering methods. Mater. Sci. Eng. C 2011, 31, 1512–1519. [Google Scholar] [CrossRef]
- Wang, C.; Hu, Q.; Huang, J.; Zhu, C.; Deng, Z.; Shi, H.; Wu, L.; Liu, Z.; Cao, Y. Enhanced hydrogen production by water splitting using Cu-doped TiO2 film with preferred (001) orientation. Appl. Surf. Sci. 2014, 292, 161–164. [Google Scholar] [CrossRef]
- Norambuena, G.A.; Patel, R.; Karau, M.; Wyles, C.C.; Jannetto, P.J.; Bennet, K.E.; Hanssen, A.D.; Sierra, R.J. Antibacterial and biocompatible titanium-copper oxide coating may be a potential strategy to reduce periprosthetic infection: An in vitro study. Clin. Orthop. Relat. Res. 2017, 475, 722–732. [Google Scholar] [CrossRef] [PubMed]
- Sarma, B.K.; Pal, A.R.; Bailung, H.; Chutia, J. Growth of nanocrystalline TiO2 thin films and crystal anisotropy of anatase phase deposited by direct current reactive magnetron sputtering. Mater. Chem. Phys. 2013, 139, 979–987. [Google Scholar] [CrossRef]
- Agnarsson, B.; Magnus, F.; Tryggvason, T.K.; Ingason, A.S.; Leosson, K.; Olafsson, S.; Gudmundsson, J.T. Rutile TiO2 thin films grown by reactive high power impulse magnetron sputtering. Thin Solid. Films 2013, 545, 445–450. [Google Scholar] [CrossRef]
- Zhang, H.; Banfield, J.F. Understanding Polymorphic Phase Transformation Behavior during Growth of Nanocrystalline Aggregates: Insights from TiO2. J. Phys. Chem. B 2000, 104, 3481–3487. [Google Scholar] [CrossRef]
- Yousefi, S.; Ghasemi, B.; Nikolova, M.P. Morpho/Opto-structural Characterizations and XRD-Assisted Estimation of Crystallite Size and Strain in MgO Nanoparticles by Applying Williamson–Hall and Size–Strain Techniques. J. Clust. Sci. 2022, 33, 2197–2207. [Google Scholar] [CrossRef]
- Hossain, M.S.; Sarkar, S.; Tarannum, S.; Tuntun, S.M.; Mahmud, M.; Bin Mobarak, M.; Ahmed, S. Exploration of photo-catalytic activity of nano-hydroxyapatite based on the crystallographic parameters: Estimation of crystallite size using X-ray diffraction data. J. Saudi Chem. Soc. 2023, 27, 101769. [Google Scholar] [CrossRef]
- Kokubo, T.; Kushitani, H.; Sakka, S.; Kitsugi, T.; Yamamuro, T. Solutions able to reproduce in vivo surface-structure changes in bioactive glass-ceramic A-W. J. Biomed. Mater. Res. 1990, 24, 721–734. [Google Scholar] [CrossRef]
- Hirpara, J.; Chawla, V.; Chandra, R. Investigation of tantalum oxynitride for hard and anti-corrosive coating application in diluted hydrochloric acid solutions. Mater. Today Commun. 2020, 23, 101113. [Google Scholar] [CrossRef]
- Thornton, J.A. The microstructure of sputter-deposited coatings. J. Vac. Sci. Technol. A. 1986, 4, 3059–3065. [Google Scholar] [CrossRef]
- Veisfeld, N.; Geller, J.D. Ion Sputtering Yield Measurements for Submicrometer Thin Film. J. Vac. Sci. Technol. A 1998, 6, 2077–2081. [Google Scholar] [CrossRef]
- Seshan, K. Handbook of Thin Film Deposition, 3rd ed.; Elsevier Inc.: Amsterdam, The Netherlands, 2012; p. 392. ISBN 9781437778748. [Google Scholar]
- Zheng, J.; Bao, S.; Guo, Y.; Jin, P. TiO2 films prepared by dc reactive magnetron sputtering at room temperature: Phase control and photocatalytic properties. Surf. Coat. Technol. 2014, 240, 293–300. [Google Scholar] [CrossRef]
- Nezar, S.; Saoula, N.; Sali, S.; Faiz, M.; Mekki, M.; Aïcha Laoufi, N.; Tabet, N. Properties of TiO2 thin films deposited by rf reactive magnetron sputtering on biased substrates. Appl. Surf. Sci. 2017, 395, 172–179. [Google Scholar] [CrossRef]
- Nikolova, M.P.; Tzvetkov, I.; Dimitrova, T.V.; Ivanova, V.L.; Handzhiyski, Y.; Andreeva, A.; Valkov, S.; Ormanova, M.; Apostolova, M.D. Effect of Co-Sputtered Copper and Titanium Oxide Coatings on Bacterial Resistance and Cytocompatibility of Osteoblast Cells. Nanomaterials 2024, 14, 1148. [Google Scholar] [CrossRef] [PubMed]
- Alotaibi, A.M.; Williamson, B.A.D.; Sathasivam, S.; Kafizas, A.; Alqahtani, M.; Sotelo-Vazquez, C.; Buckeridge, J.; Wu, J.; Nair, S.P.; Scanlon, D.O.; et al. Enhanced Photocatalytic and Antibacterial Ability of Cu-Doped Anatase TiO2 Thin Films: Theory and Experiment. ACS Appl. Mater. Interfaces 2020, 12, 15348–15361. [Google Scholar] [CrossRef] [PubMed]
- Lin, J.; Wang, B.; Sproul, W.D.; Ou, Y.; Dahan, I. Anatase and rutile TiO2 films deposited by arc-free deep oscillation magnetron sputtering. J. Phys. D Appl. Phys. 2013, 46, 084008. [Google Scholar] [CrossRef]
- Kulikovsky, V.; Ctvrtlik, R.; Vorlicek, V.; Filip, J.; Bohac, P.; Jastrabik, L. Mechanical properties and structure of TiO2 films deposited on quartz and silicon substrates. Thin Solid. Films 2013, 542, 91–99. [Google Scholar] [CrossRef]
- Sprague, J.; Gilmore, C. Molecular dynamics simulations of film-substrate interface mixing in the energetic deposition of FCC metals. Thin Solid. Films 1996, 272, 244–254. [Google Scholar] [CrossRef]
- Vrakatseli, V.; Farsari, E.; Mataras, D. Wetting Properties of Transparent Anatase/Rutile Mixed Phase Glancing Angle Magnetron Sputtered Nano-TiO2 Films. Micromachines 2020, 11, 616. [Google Scholar] [CrossRef]
- Rowley, D.I. Orthopaedic Basic Science, Foundations of Clinical Practice, 3rd ed.; Einhorn, T.A., O’Keefe, R.J., Buckwalter, J.A., Eds.; American Academy of Orthopaedic Surgeons: Rosemont, IL, USA, 2007; p. 465. ISBN 13-9780892033577. [Google Scholar] [CrossRef]
- Hidalgo-Robatto, B.M.; López-Álvarez, M.; Azevedo, A.S.; Dorado, J.; Serra, J.; Azevedo, N.F.; González, P. Pulsed laser deposition of copper and zinc doped hydroxyapatite coatings for biomedical applications. Surf. Coat. Technol. 2018, 333, 168–177. [Google Scholar] [CrossRef]
- Li, S.; Liu, Y.; Zheng, Z.; Liu, X.; Huang, H.; Han, Z.; Ren, L. Biomimetic robust superhydrophobic stainless-steel surfaces with antimicrobial activity and molecular dynamics simulation. Chem. Eng. J. 2019, 372, 852–861. [Google Scholar] [CrossRef]
- Shen, Q.; Qi, Y.; Kong, Y.; Bao, H.; Wang, Y.; Dong, A.; Wu, H.; Xu, Y. Advances in Copper-Based Biomaterials with Antibacterial and Osteogenic Properties for Bone Tissue Engineering. Front. Bioeng. Biotechnol. 2022, 20, 795425. [Google Scholar] [CrossRef] [PubMed]
- Wang, Z.; Li, N.; Zhao, J.; White, J.C.; Qu, P.; Xing, B. CuO nanoparticle interaction with human epithelial cells: Cellular uptake, location, export, and genotoxicity. Chem. Res. Toxicol. 2012, 25, 512–521. [Google Scholar] [CrossRef] [PubMed]
- Espana-Sanchez, B.L.; Avila-Orta, C.A.; Padilla-Vaca, L.F.; Barriga-Castro, E.D.; Soriano-Corral, F.; Gonzalez-Morones, P.; Ramírez-Wong, D.G.; Luna-Bárcenas, G. Early stages of antibacterial damage of metallic nanoparticles by TEM and STEM-HAADF. Curr. Nanosci. 2017, 14, 54–61. [Google Scholar] [CrossRef] [PubMed]
- Liu, T.Y.; Liao, H.C.; Lin, C.C.; Hu, S.H.; Chen, S.Y. Biofunctional ZnO nanorod arrays grown on flexible substrates. Langmuir 2006, 22, 5804–5809. [Google Scholar] [CrossRef]
- Liu, F.; SunIon, D. Distribution and Hydration Structure at Solid–Liquid Interface between NaCl Crystal and Its Solution. ACS Omega 2019, 4, 18692–18698. [Google Scholar] [CrossRef]

| Sample Bias Voltage | Ti Content, (wt.%) ± SD | Cu Content, (wt.%) ± SD |
|---|---|---|
| −25 V | 68.95 ± 0.15 | 2.62 ± 0.02 |
| −50 V | 68.48 ± 0.41 | 2.34 ± 0.16 |
| −75 V | 67.98 ± 0.76 | 2.13 ± 0.38 |
| −100 V | 68.14 ± 0.33 | 2.11 ± 0.21 |
| Sample | Phase/Plane | FWHM, (Degree) | Grain Size, (nm) | Dislocation Density (1015 lines/m2) | Micro-Strain | Wrutile, % | Wanatase, % |
|---|---|---|---|---|---|---|---|
| −25 V | Anatase (101) | 0.8373 | 9.72 | 10.58 | 0.016 | 0 | 100 |
| −50 V | Anatase (101) | 0.9848 | 8.26 | 14.65 | 0.019 | 14.6 | 85.4 |
| −75 V | Anatase (101) | 1.0630 | 7.66 | 17.05 | 0.021 | 21.3 | 78.7 |
| −100 V | Rutile (110) | 1.4622 | 5.60 | 31.93 | 0.026 | 100 | 0 |
| Sample | KH0.005, kgf/mm2 | Lc (N) | COF |
|---|---|---|---|
| Substrate | 778 ± 39 | - | 0.43 ± 0.040 |
| −25 V | 1365 ± 16 | 8.4 ± 0.8 | 0.27 ± 0.012 |
| −50 V | 2108 ± 207 | 37.5 ± 1.1 | 0.23 ± 0.008 |
| −75 V | 2164 ± 195 | >50 | 0.20 ± 0.010 |
| −100 V | 3031 ± 115 | 5.4 ± 0.6 | 0.40 ± 0.022 |
| Sample | Ecorr (mV) | jcorr (10−6 A/cm2) | Rp (kOhms) | P.E (%) |
|---|---|---|---|---|
| Ti6Al4V substrate | −118 | 10.1 | 18.2 | - |
| Coated −25 V | −145 | 5.4 | 33.5 | 46.5 |
| Coated −50 V | −122 | 2.7 | 93.6 | 73.3 |
| Coated −75 V | −140 | 3.8 | 4.0 | 62.4 |
| Coated −100 V | −159 | 3.9 | 36.3 | 61.4 |
Disclaimer/Publisher’s Note: The statements, opinions and data contained in all publications are solely those of the individual author(s) and contributor(s) and not of MDPI and/or the editor(s). MDPI and/or the editor(s) disclaim responsibility for any injury to people or property resulting from any ideas, methods, instructions or products referred to in the content. |
© 2024 by the authors. Licensee MDPI, Basel, Switzerland. This article is an open access article distributed under the terms and conditions of the Creative Commons Attribution (CC BY) license (https://creativecommons.org/licenses/by/4.0/).
Share and Cite
Nikolova, M.P.; Yousefi, S.; Handzhiyski, Y.; Apostolova, M.D. One-Step Magneton Sputtering of Crystalline Cu-Doped TiO2 Coatings: Characterization and Antibacterial Activity. Appl. Sci. 2024, 14, 9578. https://doi.org/10.3390/app14209578
Nikolova MP, Yousefi S, Handzhiyski Y, Apostolova MD. One-Step Magneton Sputtering of Crystalline Cu-Doped TiO2 Coatings: Characterization and Antibacterial Activity. Applied Sciences. 2024; 14(20):9578. https://doi.org/10.3390/app14209578
Chicago/Turabian StyleNikolova, Maria P., Sadegh Yousefi, Yordan Handzhiyski, and Margarita D. Apostolova. 2024. "One-Step Magneton Sputtering of Crystalline Cu-Doped TiO2 Coatings: Characterization and Antibacterial Activity" Applied Sciences 14, no. 20: 9578. https://doi.org/10.3390/app14209578
APA StyleNikolova, M. P., Yousefi, S., Handzhiyski, Y., & Apostolova, M. D. (2024). One-Step Magneton Sputtering of Crystalline Cu-Doped TiO2 Coatings: Characterization and Antibacterial Activity. Applied Sciences, 14(20), 9578. https://doi.org/10.3390/app14209578

